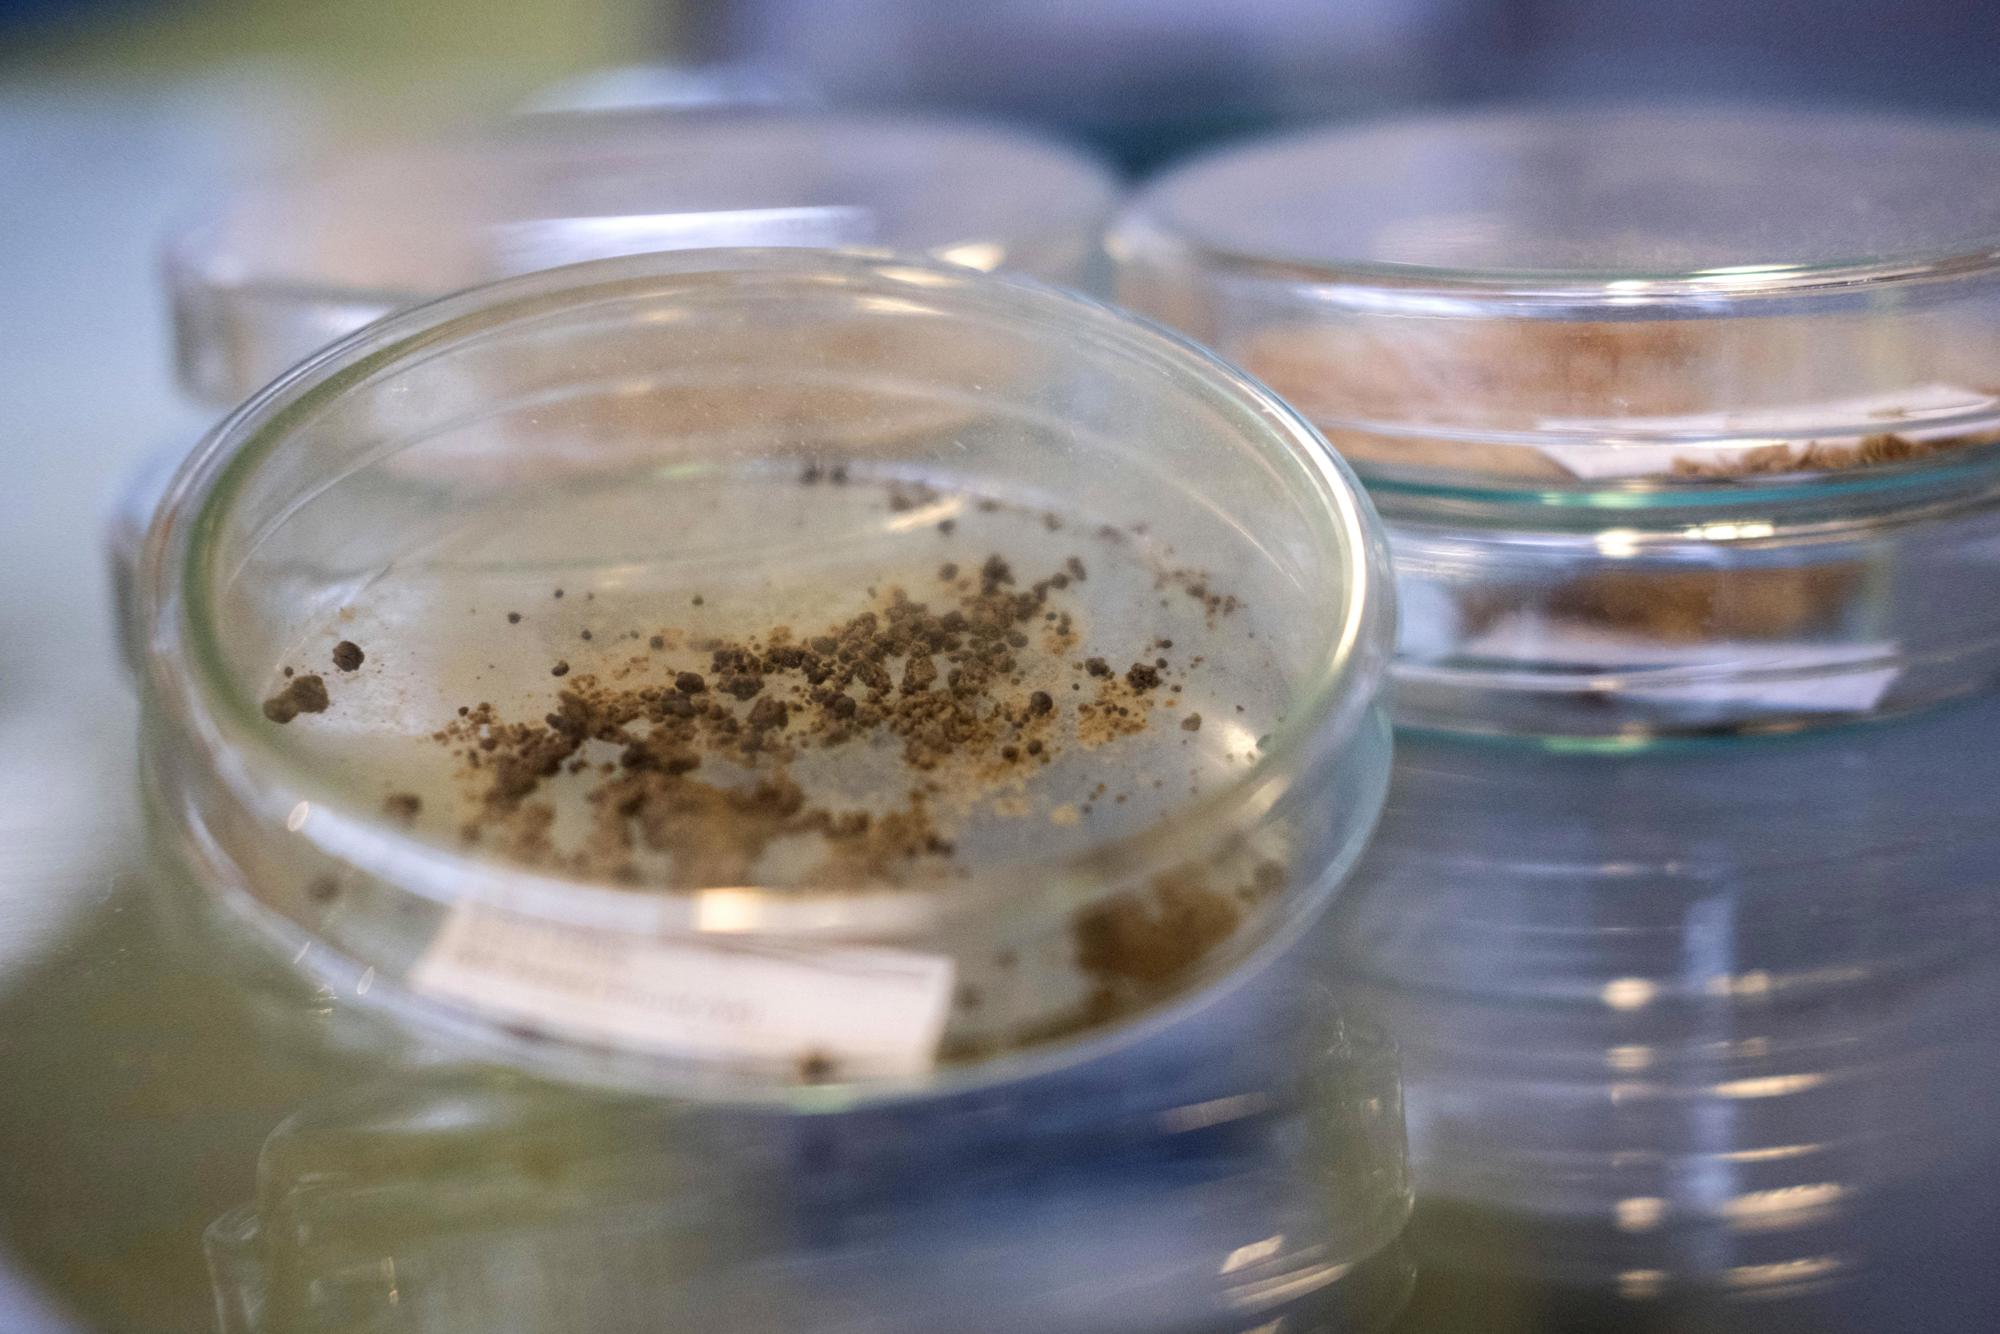

Lees hoe uitvinders werken aan een duurzame economie, met hernieuwbare grondstoffen uit onze afvalberg.

De vrienden van Willem Sederel beschrijven hem als ‘een hardwerkende, gepassioneerde businessman, die alles even interessant vindt en problemen snel kan doorgronden’. Zelfs nu hij officieel met pensioen is, werkt hij nog 40, 50 uur per week. “Maar ik ben daar een beetje zoekende in; ik wil meer tijd besteden aan mijn gezin en mijn kleinkinderen. En wat vaker met mijn vrouw onze favoriete musea bezoeken.” Zoals De Pont in Tilburg. “Die hebben zúlke mooie tentoonstellingen.”
Willem werkte 36 jaar in de petrochemische industrie, voor internationale bedrijven die plastics produceren: kunststoffen voor eindeloos veel toepassingen. Voor de verpakkingssector, maar ook voor gebruiksvoorwerpen als helmen of auto-onderdelen. Hij is een van de initiatiefnemers van de Green Chemistry Campus in Bergen op Zoom. Hier werken duurzame ondernemingen in open innovatie aan groene chemie, voor de transitie naar een duurzame economie. Hoe komt het dat iemand ‘uit de olie’ zijn focus verlegt naar de biobased economy?
Scheikundeleraar dr. Van Woerkom bracht Willem Sederel de liefde voor het vak bij. “Hij kon mooi vertellen. Over verrassende uitkomsten van chemische proeven, of over hoe bepaalde materialen gemaakt worden. Scheikunde kom je overal in het leven tegen, al is het vaak verborgen.” Na zijn studie en promotie in (natuurlijk) scheikunde kwam hij via Shell Research als productontwikkelaar bij General Electric in Bergen op Zoom terecht.
“Bij GE Plastics heb ik een fantastische tijd meegemaakt. Ik heb er ontzettend veel geleerd.” In 2007 werd GE overgenomen door het Saoedische SABIC. Als innovatieleider plastics was Willem betrokken bij de ontwikkeling van de cd, de dvd en polycarbonaat, een extreem harde en taaie kunststof. “Polycarbonaat is op de maan geweest! Daar werden astronautenhelmen van gemaakt.”
Als geen ander weet Willem Sederel dat innoveren een lastige tak van sport is. Van de tien vernieuwende ideeën die worden uitgewerkt, haalt de helft het niet. “Maar vernieuwingen in de chemie kunnen echte gamechangers zijn, met wereldwijde impact – bijvoorbeeld op het milieu. Duurzaamheid is zo’n belangrijk thema: voor de volgende generaties móeten we de planeet goed achterlaten. De wereld staat er niet geweldig voor, maar ik ben optimistisch. Bepaalde problemen kunnen we nú aanpakken.” Dat wil Willem ook voor zijn zes kleinkinderen. Hij noemt zichzelf een hands on opa. “Stoeien, verhaaltjes voorlezen… maar ik geef ze ook graag wat mee. Als ik vertel dat ik in de Rotterdamse haven ben geweest, hangen ze aan mijn lippen.”
Zijn belangstelling voor duurzame en hernieuwbare grondstoffen ontstond rond 2003. Klanten vroegen om niet-fossiele materialen, want de consument wilde duurzamere producten. Zeker Scandinavië was al ver op dat gebied. “Er was vraag, dus het moest wel succesvol worden.” Samen met klanten bekeek GE Plastics de levenscyclusanalyse en CO2-voetafdruk. Olie als grondstof was niet langer vanzelfsprekend. “Dat was een heel ander speelveld. Uit plantaardig materiaal konden we heel andere producten maken, die van nature antibacterieel waren of een betere zuurstofbarrière hadden.”
De eerste aanzet tot de Green Chemistry Campus (GCC) was in 2009. De Regionale Ontwikkelingsmaatschappij West Brabant (REWIN) vroeg bedrijven uit West-Brabant en Zeeland: kan uw afval de grondstof zijn voor uw buurman? Ook SABIC (founding partner) was van de partij. Willem: “Het resultaat was dat ongeveer de helft van die bedrijven een gezamenlijke agenda schreef, die we aan de topsectoren aanboden. Het thema: Agro Meets Chemistry.”
De bedrijven wilden een locatie waar innovatieve biobased producten konden worden ontwikkeld. Dat kwam er, op het terrein van SABIC in Bergen op Zoom. Een op zichzelf staand gebouw perfect voor het doel. “We kregen toestemming van het hoogste niveau van SABIC, vanuit Riyad. Nu zit daar het Campus Innovation Center van de GCC.” Partners zijn de provincie Noord-Brabant, REWIN en de gemeente Bergen op Zoom. In 2011 is de Green Chemistry Campus van start gegaan met 3 bedrijven. Ondertussen zijn dat er 11; allemaal jonge technologiebedrijven die zich focussen op biobased technieken.
Wat de bedrijven op de GCC bedenken en produceren, wordt de innovatiemotor voor het MKB. Die vervolgens de grotere bedrijven aanjagen in hun vergroening en zorgen dat de biobased economy een feit wordt: een circulaire economie op basis van reststoffen en biomassa. Willem: “Duurzaamheid is een thema wereldwijd, maar ook persoonlijk. Je eigen keuzes en gedrag hebben invloed. Zo zijn mijn vrouw en ik bewust flexitariër. En als we naar Duitsland gaan, nemen we de trein in plaats van het vliegtuig.”
De transitie naar een groene economie is niet optioneel, zegt hij, en zal in eerste instantie chaos veroorzaken. “We moeten een andere manier van denken ontwikkelen, minder aan privébezit gaan hechten.” Lachend: “Ik deel zelf al mijn zeilboot met een groepje jonge zeilers van mijn club. Ontzettend leuk. Je leert zóveel van jonge mensen!”
Willem Sederel is overtuigd van de commerciële potentie van de GCC: “Veel van de bedrijven daar gaan voor banen zorgen in de regio. En een paar, zoals Biorizon en NNRGY Crops, zijn echte gamechangers.” NNRGY Crops maakt uit het snelgroeiende olifantsgras milieuvriendelijk papier, bioplastic en bouwmateriaal. Biorizon ontwikkelt een productieproces voor bio-aromaten uit plantaardig restafval. Daar wordt bijvoorbeeld verf en cosmetica van gemaakt. Beide bedrijven hebben op de korte termijnplannen voor fabrieken. Willem Sederel: “In 2025 kopen mijn kinderen en kleinkinderen producten uit de koker van de Green Chemistry Campus, je zult het zien!”
Petra Koenders, directeur Green Chemistry Campus: “Begin 2018 is de bouw van onze demohal gestart met labs, voor proces- en productexperimenten. Komende zomer nemen nieuwe bedrijven daar hun intrek. GCC biedt bedrijven die hun biobased innovaties willen opschalen huur van labfaciliteiten en werkruimtes, of ondersteuning bij financiering, marketing en bedrijfsvoering. We willen meer bedrijven aan elkaar koppelen, voor kruisbestuivingen.” Een ander voordeel van de locatie in Bergen op Zoom: de vele agrarische bedrijven daar, leveranciers van biomassa.

Met één druk op de knop kopieer je gratis de volledige tekst van dit verhaal